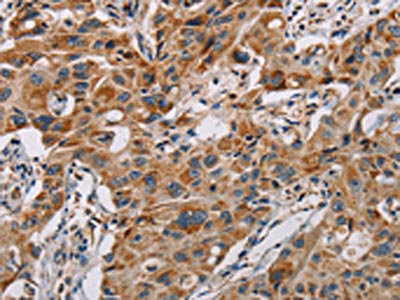

MMP1 Antibody
-
中文名稱:MMP1兔多克隆抗體
-
貨號:CSB-PA563995
-
規格:¥1100
-
圖片:
-
The image on the left is immunohistochemistry of paraffin-embedded Human liver cancer tissue using CSB-PA563995(MMP1 Antibody) at dilution 1/60, on the right is treated with fusion protein. (Original magnification: ×200)
-
The image on the left is immunohistochemistry of paraffin-embedded Human lung cancer tissue using CSB-PA563995(MMP1 Antibody) at dilution 1/60, on the right is treated with fusion protein. (Original magnification: ×200)
-
Gel: 12%SDS-PAGE, Lysate: 80 μg, Lane 1-3: PC3 cells, mouse muscle tissue, A375 cells, Primary antibody: CSB-PA563995(MMP1 Antibody) at dilution 1/500, Secondary antibody: Goat anti rabbit IgG at 1/8000 dilution, Exposure time: 1 minute
-
-
其他:
產品詳情
-
Uniprot No.:
-
基因名:
-
別名:27 kDa interstitial collagenase antibody; CLG antibody; CLGN antibody; collagenase; fibroblast antibody; collagenase; interstitial antibody; Fibroblast collagenase antibody; Interstitial collagenase antibody; Matrix metallopeptidase 1 (interstitial collagenase) antibody; Matrix metalloprotease 1 antibody; Matrix Metalloproteinase 1 antibody; Matrix metalloproteinase-1 antibody; MMP 1 antibody; MMP-1 antibody; MMP1 antibody; MMP1_HUMAN antibody; OTTHUMP00000045866 antibody
-
宿主:Rabbit
-
反應種屬:Human,Mouse
-
免疫原:Fusion protein of Human MMP1
-
免疫原種屬:Homo sapiens (Human)
-
標記方式:Non-conjugated
-
抗體亞型:IgG
-
純化方式:Antigen affinity purification
-
濃度:It differs from different batches. Please contact us to confirm it.
-
保存緩沖液:-20°C, pH7.4 PBS, 0.05% NaN3, 40% Glycerol
-
產品提供形式:Liquid
-
應用范圍:ELISA,WB,IHC
-
推薦稀釋比:
Application Recommended Dilution ELISA 1:2000-1:5000 WB 1:200-1:1000 IHC 1:50-1:200 -
Protocols:
-
儲存條件:Upon receipt, store at -20°C or -80°C. Avoid repeated freeze.
-
貨期:Basically, we can dispatch the products out in 1-3 working days after receiving your orders. Delivery time maybe differs from different purchasing way or location, please kindly consult your local distributors for specific delivery time.
-
用途:For Research Use Only. Not for use in diagnostic or therapeutic procedures.
相關產品
靶點詳情
-
功能:Cleaves collagens of types I, II, and III at one site in the helical domain. Also cleaves collagens of types VII and X. In case of HIV infection, interacts and cleaves the secreted viral Tat protein, leading to a decrease in neuronal Tat's mediated neurotoxicity.
-
基因功能參考文獻:
- For MMP-1(-1607) 1G/2G, a significant association was observed using the recessive genetic model. In the subgroup studies, a significant association was observed in the Asian subgroup (OR = 1.68; for the recessive model; and OR = 1.59; for the allelic contrast model) and in the European subgroup (OR = 0.65; for the allelic contrast model). PMID: 30117779
- rs1799750 in MMP1 might be a risk factor for rheumatic heart disease in a Han population in Southern China, and individuals carrying the 2G/2G genotype are likely more susceptible to rheumatic heart disease. PMID: 29458338
- RHCG Suppresses Tumorigenicity and Metastasis in Esophageal Squamous Cell Carcinoma via Inhibiting NF-kappaB Signaling and MMP1 Expression. PMID: 29290801
- Malignant extracellular vesicles carrying MMP1 mRNA facilitate peritoneal dissemination in ovarian cancer. PMID: 28262727
- Data suggest that matrix metalloproteinase-1 and neutrophil elastase may be important but heretofore unrecognized players in stimulating uterine contractions at the time of labor, and they may explain why indomethacin delays, but does not prevent, preterm labor because indomethacin inhibits the prostaglandin component but not the protease component of labor. PMID: 28954603
- the present study demonstrated that scopoletin inhibited MMP1 and proinflammatory cytokine expression by inhibiting p38 MAPK phosphorylation. PMID: 30015831
- Matrix metalloproteinase 1(MMP1), which was downregulated in myelodysplastic syndromes (MDS)-mesenchymal stromal cells (MSCs), was identified as an inhibitory factor of MDS cell proliferation. PMID: 28262842
- study to explore the relationship between 2 polymorphisms (MMP-1-755 T/G [rs498186] and MMP-3 A/C [rs632478]) and disc degeneration; no significant association of the MMP-1 polymorphism with disc degeneration was found PMID: 28497435
- Expression of GSDMC is increased by UV irradiation in human skin keratinocytes. GSDMC induction contributes to the increase of MMP-1 expression specifically via activation of ERK and JNK pathways. PMID: 29428815
- our results suggest that the typical 1G/2G MMP-1 polymorphic site did not play a direct determinant role in breast cancer among Taiwanese women. PMID: 29695550
- The maternal and fetal 1G/1G MMP1 gene polymorphisms may be strong genetic markers of preeclampsia, occurring either individually or together. PMID: 29670668
- The current study indicated that MMP1 has a key role in the regulation of cervical tumor growth and lymph node metastasis via epithelial mesenchymal transition to a certain extent PMID: 29436615
- 2G allele of MMP-1, C allele of MMP-2 and 5A/6A genotype of MMP-3 are associated with susceptibility and disease progression of type 2 diabetic nephropathy PMID: 29883760
- this study provides insights into the development of a possible alternative therapy manipulating MMP-1 and the mTOR signaling pathway in Epidermal growth factor receptor-tyrosine kinase inhibitor-resistant lung adenocarcinoma. PMID: 29463039
- Specific silencing that targeted AMPK resulted in the enhancement of mobility and contractility and in the production of MMP-1 and MMP-2. PMID: 29122080
- MMP-1 genotype may accelerate the development of HIV-associated neurocognitive disorder (HAND) whereas MMP3 -1612 5A5A genotype may reduce the risk of pathogenesis of HAND. PMID: 29358561
- Authors observed a significant increase in the immunoexpression of collagen I and III in patients with DCM and a significant reduction in the immunoexpression of MMP-1 compared with the control group. Also, the collagen I and TIMP-1 expression indicated a positive linear correlation and respectively a negative linear relationship with collagen III and MMP-1. PMID: 29250654
- findings suggest that the polymorphic genotypes at MMP-1 promoter -1607 may play a major role in determining personal cancer susceptibility for prostate cancer in Taiwan PMID: 29970511
- No significant association was found between MMP-1 (-16071G/2G, -519A/G) variants and obesity. PMID: 29317790
- Reduced expression of types I and III collagen and TIMP-1 as well as the increased expression of MMP-1 and MMP-8 in the anterior vaginal wall tissues play important roles in the onset of pelvic organ prolapse. PMID: 29263043
- The results of the present study suggested that miR93 regulated MMP1 and collagen I expression in fibroblasts via calpain2. miR93 mediated collagen expression in stress urinary incontinence via calpain2. PMID: 29115452
- This study demonstrates that matrix remodeling caused by matrix metalloproteinase (MMP)-1 regulates phenotypic activities and modulates radiosensitivity of hepatocarcinoma cells exclusively in a 3D matrix. In response to MMP-1, liver cancer cells undergo active proliferation, downregulation of E-cadherin, and the loss of detoxification capacity. PMID: 28683186
- Results suggested that miR-361 directly inhibited MMP-1 expression by binding to its 3'-UTR suppressing breast cancer cells invasion and metastasis. PMID: 29132384
- Review/Meta-analysis: MMP-1 -1607 1G/2G and MMP-12 -82 A/G gene polymorphisms are associated with ischemic stroke risk. PMID: 28958661
- Results show that head and neck squamous cell carcinoma tumors with low P120CTN and PI3K pathway mutations have higher levels of MMP1 compared to tumors with high P120CTN and no PI3K pathway mutations demonstrating that P120CTN downregulation and PIK3CA mutations promote MMP1-driven invasion. PMID: 28637905
- MMP-1 (and MMP-2 and MMP-3) are independently associated with markers of arterial stiffening in patients with type 1 diabetes. PMID: 29070037
- There was no statistically significant difference in the distribution of the MMP1-1607dupG (rs1799750) polymorphism between patients with unstable angina and the control group. PMID: 29044936
- PTEN inhibits replicative senescence-induced MMP-1 expression by regulating NOX4-mediated reactive oxygen species in human dermal fibroblasts. PMID: 28557373
- None of the studied polymorphisms showed statistically significant association with the risk of varicose veins of the lower extremities. PMID: 28944430
- Matrix metalloproteinase 1 rs1799750 polymorphism was significantly associated with nasopharyngeal carcinoma risk in the subgroup analysis by smoking, a marginally significant association was found in non-smokers. PMID: 29096757
- Studied the association between the matrix metalloproteinase-1 (MMP-1) 1607 1G/2G polymorphism and susceptibility to spinal tuberculosis in Southern Chinese Han population. PMID: 28129430
- MMP1 was consistently and significantly upregulated in the induced pluripotent stem cells-derived endothelia from autosomal dominant polycystic kidney disease patients with intracranial aneurysms compared with the patients without intracranial aneurysms in multiple assays, indicating that high serum MMP1 levels may be a novel risk factor. PMID: 27418197
- rs1144393 in the MMP1 promoter region can be a predictor of grade >/= 2 RILI in lung cancer patients treated with thoracic radiation. PMID: 27659527
- The present results suggested that Icariin may have a chondroprotective effect, exerted through the inhibition of MMP1, MMP3 and MMP13 via MAPK pathways. Therefore, Icariin may have potential as a novel therapeutic strategy for the treatment of osteoarthritis. PMID: 28447732
- proteolysis of collagen-rich natural extracellular matrix (ECM), performed uniquely by individual homologous proteases, leads to distinct events that eventually affect overall ECM morphology, viscoelastic properties, and molecular composition. PMID: 27630193
- SAA1 can be a potential mediator for UV-induced MMP-1 expression in human skin. PMID: 26900010
- collagen II-activated phosphorylated-DDR2 induces CYR61 through activation of transcription factor activator protein 1 (AP-1). The elevated CYR61, in turn, accelerates MMP1 production via ETS1 (ETS proto-oncogene 1). PMID: 27653023
- M. tuberculosis infection caused enhanced MMP-1, -9, and miR-223 expression, with inhibited BMAL1 expression. MiR-223 modulated BMAL1 expression via the direct binding of BMAL1 3'-UTR. PMID: 28543681
- 20(S)-PPD treatment modulated MMP-1 mRNA expression and the transcriptional activity of activator protein (AP)-1, a major transcription factor of MMP-1. PMID: 28379603
- This is the first study to indicate that the genotypes of MMP1 promoter -1607, do not significantly confer susceptibility to lung cancer in a Taiwanese population. PMID: 29277780
- Matrix metalloproteinase-1, -8, -9 and the risk of cardiovascular complications in patients with CHD before and after myocardial revascularization. PMID: 29215835
- Results show that the expression level of MMP1 and TIMP1 is under the regulation of HAS2 leading to migration, invasion and EMT of oral cancer cells. PMID: 27884164
- DDC up-regulated MMP-1 in LX-2 cells through the Akt and ERK/miR-222/ETS-1 pathways. PMID: 27412967
- Meta-analysis of existing data showed that rs1799750 may affect individual susceptibility to glaucoma. PMID: 27428613
- results suggest that MMP1-1607 1G/2G, MMP3-1171 5A/6A and MMP9-1562 C/T gene polymorphisms have synergistic effect on breast cancer. The interactions of MMPs clinical risk factors such as lymph node involvement has shown a strong correlation and might influence the 5-years survival rate, suggesting their potential role in the breast carcinogenesis PMID: 28961241
- The MMP-1 -1607 (2G/1G) and -519 (A/G) polymorphisms may contribute to the onset of osteomyelitis. The 2G/2G genotype carriers had 1.605 times risk of developing osteomyelitis. In addition, frequency of -519GG genotype was obviously higher in case group than that in control group, and GG genotype related to an increased risk of osteomyelitis. Whereas, the -519G allele may be a susceptible factor for osteomyelitis. PMID: 29049163
- No differences in the distribution of the MMP-1 variants were found among Tunisian chronic obstructive pulmonary disease patients and healthy controls. Additionally, no significant association was retrieved between clinicopathologic parameters of chronic obstructive pulmonary disease, MMP-1 levels and this polymorphism. PMID: 27412345
- In American cutaneous leishmaniasis caused by Leishmania braziliensis infection, MMP1 is regulated by factors other than FLI1, and the influence of IL-6 on MMP1 was independent of its effect on FLI1. PMID: 28119029
- MMP1 was produced in the tumor compartment of prostate cancer bone metastases, highlighting its accessibility to KLK4 at this site PMID: 27378148
- EREG and MMP-1 were found to be elevated in nasal polyp and uncinate tissues in patients with Chronic rhinosinusitis with nasal polyps. PMID: 28398769
顯示更多
收起更多
-
亞細胞定位:Secreted, extracellular space, extracellular matrix.
-
蛋白家族:Peptidase M10A family
-
數據庫鏈接:
Most popular with customers
-
-
YWHAB Recombinant Monoclonal Antibody
Applications: ELISA, WB, IHC, IF, FC
Species Reactivity: Human, Mouse, Rat
-
Phospho-YAP1 (S127) Recombinant Monoclonal Antibody
Applications: ELISA, WB, IHC
Species Reactivity: Human
-
-
-
-
-